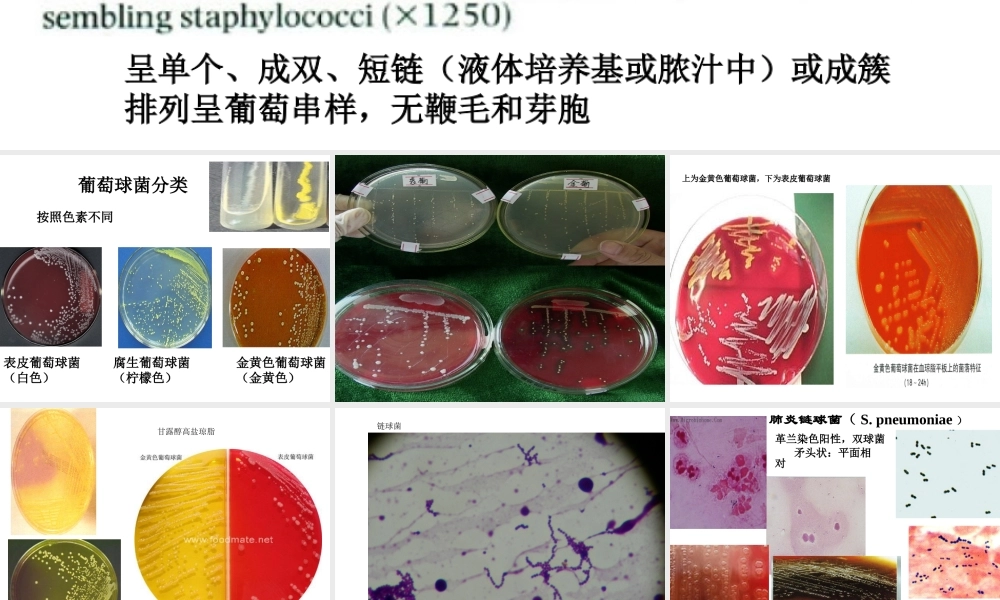
首师大小学科学六下《3.微生物》PPT课件.ppt
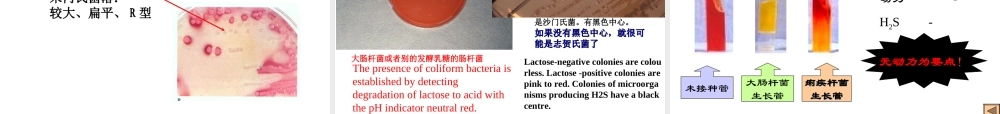
首师大小学科学六下《3.微生物》PPT课件.ppt

呈单个、成双、短链(液体培养基或脓汁中)或成簇排列呈葡萄串样,无鞭毛和芽胞葡萄球菌分类按照色素不同金黄色葡萄球菌(金黄色)表皮葡萄球菌(白色)腐生葡萄球菌(柠檬色)上为金黄色葡萄球菌金黄色葡萄球菌,下为表皮葡萄球菌表皮葡萄球菌甘露醇高盐琼脂链球菌肺炎链球菌(S.pneumoniae)矛头状:平面相对尖面相背形态与染色革兰染色阳性,双球菌无芽胞无鞭毛““脐窝状脐窝状”菌落”菌落肠球菌生物学性状及鉴定生物学性状形态与染色:G+球菌,成单、双、短链排列。血平板上α、γ溶血脑膜炎奈瑟菌(N.meningitidis)革兰阴性双球菌,肾形或豆形生物学性状形态染色:G-,呈肾型,成双排列(凹面相对,凸面相背),有荚膜及菌毛•易产生自溶酶光滑露珠样菌落光滑露珠样菌落•革兰染色阴性•肾形、成双排列•有菌毛,无芽胞和鞭毛,新分离株有荚膜淋病奈瑟菌淋病奈瑟菌大肠埃希菌电镜图2、营养要求不高普通琼脂平板:圆形凸起灰白色S型菌落;肠道鉴别培养基:有色菌落(SS培养基)大肠埃希氏菌落中央呈粉红色分离培养分离培养SSSS培养基培养基中国兰培养基中国兰培养基发酵乳糖菌落发酵乳糖菌落大肠杆菌大肠杆菌不发酵乳糖菌落不发酵乳糖菌落肠道致病菌肠道致病菌大肠埃希氏菌在伊红美蓝琼脂(EMB)上典型特征大肠埃希氏菌落呈黑色中心,有或无金属光泽EMB(伊红——美兰培养基),乳糖、伊红、美兰选择作用(弱选)大肠埃希菌(非致病菌)乳糖发酵产酸伊红结合美兰形成紫黑色金属光泽化合物有色的乳糖发酵菌落伤寒沙门菌等(致病菌)乳糖不发酵伊红美兰不能结合无色的乳糖不发酵菌落SS培养基(沙门志贺培养基)乳糖、中性红指示剂、胆盐、煌绿等抑制剂选择抑制作用(强选)大肠埃希菌产酸桃红色乳糖发酵菌落伤寒沙门菌无色乳糖不发酵菌落胆盐、煌绿:抑制大肠埃希菌及G+菌,提高肠道致病菌检出率乳糖发酵中性红呈红色乳糖不发酵常用鉴定试验常用鉴定试验甲基红试验大肠杆菌:大肠杆菌:++产气杆菌:产气杆菌:--枸橼酸盐利用试验大肠杆菌:大肠杆菌:--产气杆菌:+阳性吲哚试验大肠杆菌:大肠杆菌:++产气杆菌:-KIA培养基:A大肠埃希菌大肠埃希菌B志贺菌C阴性对照KIA培养基:A沙门菌B变形杆菌C阴性对照1.G–直杆菌有菌毛无鞭毛动力动力--((痢疾杆菌痢疾杆菌))动力动力++((大肠杆大肠杆菌菌))•营养要求不高•常选用SSSS培养基培养基(志-沙氏)–菌落:无色、半透明、较小菌落、S型–宋内氏菌落:较大、扁平、R型志贺菌属生物学特性志贺菌属生...